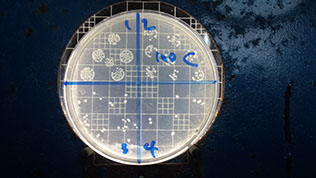

PROYECTO EFA 10-018
Modelo cinético para determinar la capacidad depurativa de hidrocarburos del microcosmos, en agua y sedimento, de la bahía de Manzanillo, zona portuaria del Canal de Panamá y su aplicación a sistemas de tratamiento biológico.
GALERÍA DE FOTOS
___________________
Divulgación Feria SENACYT - MARZO 2014
FOTOS PROYECTO EFA10-018
tESIS (ARENAS Y PÉREZ)
TESIS (GREY, A.)





<
>
























<
>










<
>

<
>
© 2010 Edgardo Santana Web Design. Valid CSS & XHTML.
Todos los Derechos Reservados